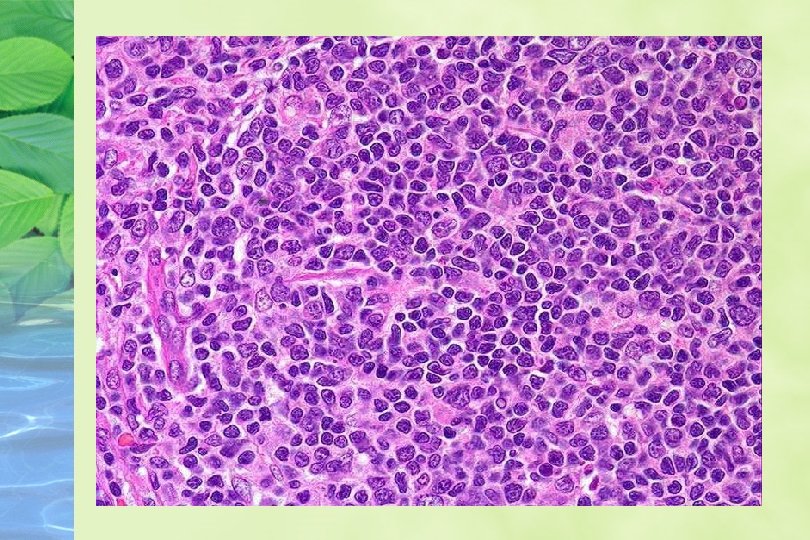
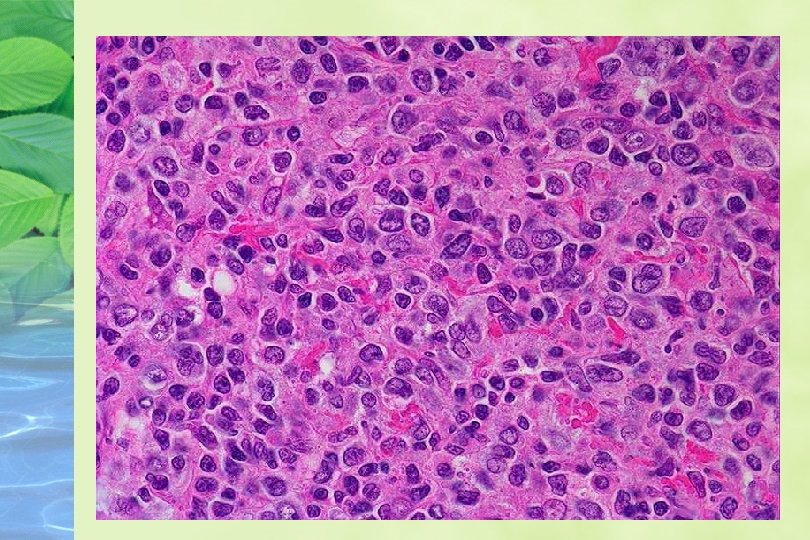

LINFOMAS FOLICULARES GRADO II MIXTO CEL PEQUEA HENDIDA
















- Slides: 16

LINFOMAS FOLICULARES GRADO II: MIXTO CEL PEQUEÑA HENDIDA, 515 DE CEL. GRANDE NO HENDIDA t (14: 18), bcl 2 s Ig, CD 19, CD 20, CD 21 SOBREVIDA 7 -9 AÑOS TRASFORMACION ALTO GRADO 1 AÑO SOBREVIDA

LINFOMA S FOLICULARES G III. CEL GRANDES NO HENDIDAS, 3 a +15 cel grandes con células pequeñas, 3 b solo cel grandes. 15% LNH GRADO INTERMEDIO POBRE PRONOSTICO Variedades difusas, clasificados como grados intermedios

LINFOMA FOLICULAR Bcl 2+, CD 20+, bcl 6+, CD 5 -, ciclina D 1 Hipermutación somática del gen de Ig 70 -90% t(14; 18)(q 32; q 21) expresión inapropiada del proteina bcl 2 5 -15% rearreglo del gen bcl 6


LINFOMA DE CELULAS DE LA ZONA DEL MANTO 1974 BERARD Y DORFMAN DEFINEN LINFOMA LINFOCITICO DE DIFERENCIACION INTERMEDIA 1977 NANBA ENCUENTRA CELULAS F. ALCALINA POSITIVAS EN FOLICULOS PRIMARIOS Y ZONAS DEL MANTO, 1/3 CASOS DE LINFOMA FOLICULAR DE CEL. PEQ. HENDIDA. WEISENBURGER 1981 -1982 DEFINE IDL COMO UNA NEOPLASIA COMPUESTA POR LINFOCITOS PEQUEÑOS CON NUCLEOS IDENTADOS O IRREGULARES WORKING FORMULATION LINFOMA LINFOCITICO, O DIFUSO DE CELULA PEQUEÑA HENDIDA.

LINFOMA DE CELULAS DE LA ZONA DEL MANTO U. S. A. REPRESENTA 2. 5% DE TODOS LINFOMAS 6% DE LOS LINFOMAS INDOLENTES O DE BAJO GRADO

CARACTERISTICAS CLINICAS Enfermedad de viejos media 58 Promedio hombres : mujeres 3: 1 Generalmente estadios avanzados al diagnostico III - IV Síntomas B Adenopatias, M. O. , hepato esplenomegalia Sangre periférica (> 4000/mm 3 ) en 13%

Patrones Difuso : sobrevida media 42 meses, recaída mas común, poca sobrevida libre de enfermedad Patrón de zona del manto : mejor pronóstico 61 meses sobrevida media, puede progresar Grado : linfoma de bajo grado, ( historia natural medida en años )

HALLAZGOS HISTOLOGICOS GANGLIO: Arquitectura reemplazada por un patrón difuso o vagamente nodular % pequeño es típicamente nodular Células neoplásicas monótonas , linfocitos pequeños de contorno nuclear irregular, cromatina condensada , nucleolo pequeño, mitosis 19/ 20 hpf

PATRON DE ZONA DEL MANTO Proliferación de células formando manguitos alrededor de centros germinales , obliteración de los sinusoides Infiltración con patrón de zona del manto se a visto en LLC, SLL con diferenciación plasmocitoide, Leucemia prolinfocitica, Linfoma monocitoide de células B, MALT linfomas,

